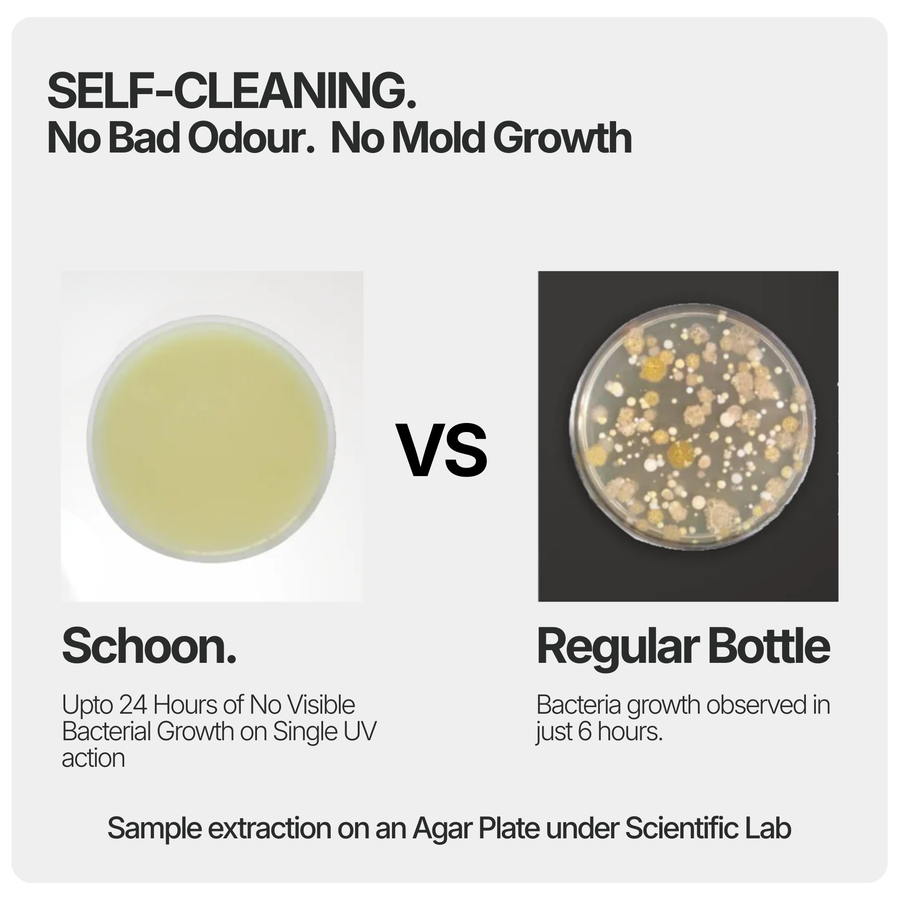

लोकप्रिय खोजें
- शून
- गो मिनी
- अल्कारिच
- नियो
- कहवा
- मैगबॉटल
- फिल्टर कारतूस
- टोपी
- यूवी ढक्कन

ताज़ा रहें, सुरक्षित रहें। फ्लेस शून उन्नत यूवी-सी स्टरलाइज़ेशन का उपयोग करके 99.9% कीटाणुओं और दुर्गंध को खत्म करता है, जिससे आपका पानी साफ़ रहता है और बोतल दिन भर दुर्गंध मुक्त रहती है। प्रीमियम स्टेनलेस स्टील से बना, यह वैक्यूम-इन्सुलेटेड, लीक-प्रूफ और जिम, यात्रा या आपके डेस्क के लिए पर्याप्त स्टाइलिश है।
बस टैप करें, जीवाणुरहित करें और घूंट-घूंट करके पियें।
रंग
क्षमता

रंग
क्षमता
Premium UV-C Smart Self-Cleaning Water Bottle
| Specification | Details | Specification | Details |
|---|---|---|---|
| UV-C Technology | 275nm wavelength | Smart Features | Hydration Reminder |
| Material | Stainless steel 316L | Certifications | FDA, CE, RoHS |
| Insulation | Double-wall vacuum | Sensor | Liquid Temperature |
| Battery | 800mAh Li-Po | Capacity | 500 ML |
| Cleaning Cycle | Manual Activation | Charging Port | USB to Type C |
| Dimensions | H: 245mm × Ø: 72mm | ||
| Weight | 380g (empty) |

Advanced UV-C LED technology eliminates 99.9% of harmful bacteria and viruses, ensuring pure, safe drinking water every time.

Smart LED indicators remind you to stay hydrated throughout the day, helping you maintain optimal health and wellness.

Premium stainless steel double-wall vacuum insulation keeps drinks cold for 24 hours or hot for 12 hours.
अक्सर पूछे जाने वाले प्रश्नों
फ्लेस शून एक यूवी-सी स्टरलाइज़ेशन स्मार्ट पानी की बोतल है जिसे मेडिकल-ग्रेड यूवी प्रकाश का उपयोग करके 99.99% बैक्टीरिया और वायरस को खत्म करने के लिए डिज़ाइन किया गया है।
गो मिनी एक पोर्टेबल वाटर प्यूरीफायर बोतल है जो इकोप के 3-स्टेज एचपीएफ-3एस नैनोटेक फिल्टर से सुसज्जित है, जो यात्रा, ट्रैकिंग और रोजमर्रा के उपयोग के लिए आदर्श है।
अल्कारिच एक क्षारीय पानी की बोतल है जो पीएच स्तर को बढ़ाती है, खनिजों को मिलाती है, और बेहतर जलयोजन और स्वास्थ्य को बढ़ावा देने के लिए ओआरपी (ऑक्सीकरण न्यूनीकरण क्षमता) को कम करती है।
हाँ। GO Mini एक शक्तिशाली HPF-3S फ़िल्टर सिस्टम का उपयोग करता है जिसमें 0.1-माइक्रोन झिल्ली, KDF55 + ज़ीओलाइट मिश्रण और सक्रिय कार्बन ब्लॉक शामिल हैं। यह बैक्टीरिया, प्रोटोज़ोआ, माइक्रोप्लास्टिक्स, भारी धातुओं, क्लोरीन और दुर्गंध को दूर करता है—जिससे लगभग कोई भी ताज़ा पानी पीने योग्य हो जाता है।
अल्कारिच पानी के पीएच स्तर को हल्का क्षारीय, आमतौर पर लगभग 8.5-9.5 , तक बढ़ा देता है और कैल्शियम, मैग्नीशियम और पोटेशियम जैसे ज़रूरी खनिज भी प्रदान करता है। क्षारीय पानी में ये गुण हो सकते हैं:
1. शरीर में अम्लता को बेअसर करने में मदद करें
2. चयापचय और जलयोजन में सुधार
3. बेहतर त्वचा और ऊर्जा स्तर का समर्थन करें
बिल्कुल। सभी ईकोप बोतलें—जिनमें फ्लेश शून, गो मिनी और अल्कारिच शामिल हैं— बीपीए-मुक्त, खाद्य-ग्रेड सामग्री से बनी हैं। रिसाव-रोधी प्रदर्शन, तापीय सुरक्षा और दीर्घकालिक स्थायित्व के लिए इनका कठोर परीक्षण किया जाता है, जिससे ये रोज़मर्रा और बाहरी उपयोग के लिए सुरक्षित हो जाती हैं।
कोई उत्पाद नहीं मिला
शीघ्र बिक्री के लिए साइन अप करें, नए,
प्रमोशन, छूट और अन्य सुविधाएँ।